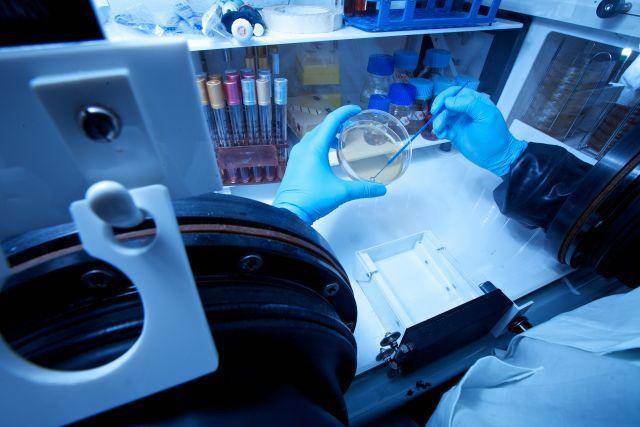
Tamponi per Covid 19 alla Fondazione Edmund Mach 1

Web Tax 2020 e ritorsioni Usa: timori per nuovi dazi sul vino. Agosto mese “caldo”
Prevenire anziché combattere. C’è preoccupazione nella filiera del vino italiano per l’apertura di nuove indagini degli Stati Uniti sulla Web Tax, provvedimento al vaglio di molti Paesi dell’Unione europea per regolamentare la tassazione di colossi americani del web come Google, Amazon e Facebook. L’Italia ha già inserito la Web Tax nel testo della Legge di […]
Web Tax 2020 e ritorsioni Usa: timori per nuovi dazi sul vino. Agosto mese “caldo” Leggi tutto »